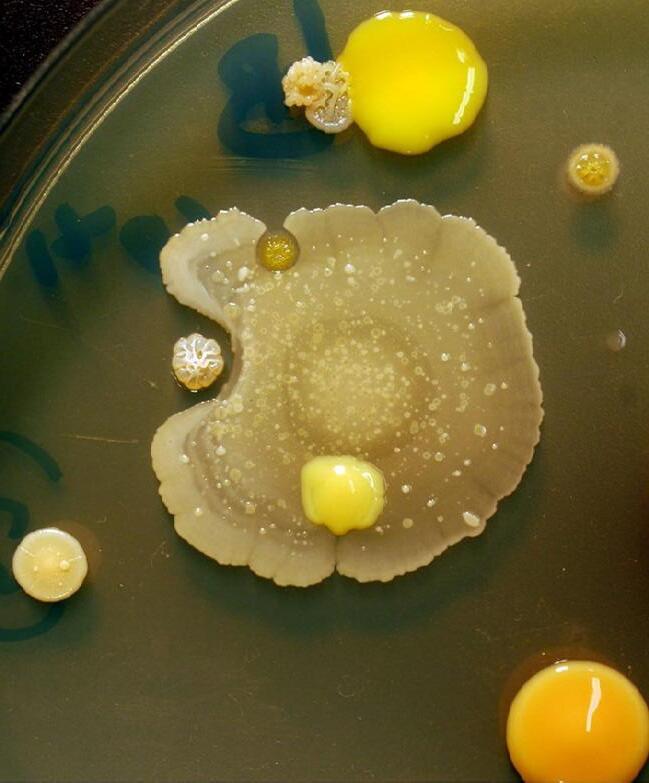

Ós mo sis
Retroalimentando la innovación docente desde fuera y dentro de la Universidad


Retroalimentando la innovación docente desde fuera y dentro de la Universidad

El Programa Ósmosis es una iniciativa de los Vicerrectorados de Investigación e Innovación y de Planificación, dirigida a profesorado no universitario dispuesto a promover e implementar metodologías innovadoras en sus centros de referencia, además de colaborar con el profesorado y alumnado de la UMH. Se trata de un programa original que surge a raíz de un curso de orientadores web para profesores de centros, impartido por la propia vicerrectora adjunta: “En esta sesión, al comentar proyectos de innovación que la Universidad estaba desarrollando, mostré a los orientadores los vídeos promocionales de los grados que se imparten en la Universidad y pensaron que serían un recurso magnífico para promocionar los ciclos formativos e integrarlos en sus programas de orientación. Con el objetivo de que ellos también pudieran trabajar en sus propios vídeos, les puse en contacto con profesorado de Periodismo y Comunicación Audiovisual”. Tal y como explica Martínez Mayoral, éste fue el germen de la iniciativa, en el que la profesora María Teresa Zaragoza implicó a sus estudiantes, a través de la asignatura Guion II, en la que algunas de las prácticas estuvieron orientadas hacia la creación de vídeos para programas formativos de ciclos de Formación Profesional en diferentes centros.
El término ósmosis hace referencia al proceso físico-químico relacionado con el paso de un disolvente, por ejemplo, moléculas de agua, a través de una membrana semipermeable. Y precisamente haciendo alusión a ese trasvase, se ha bautizado como Programa Ósmosis a la iniciativa puesta en marcha por la Universidad Miguel Hernández (UMH) de Elche para fomentar el desarrollo de proyectos de innovación educativa financiados con fondos públicos en centros de primaria y secundaria, tanto de titularidad pública como privada. Según la vicerrectora adjunta de Investigación e Innovación para la Innovación Tecnológica, mª Asunción martínez mayoral, el objetivo del proyecto es conectar a la Universidad con los colegios y que se fomente el intercambio de experiencias innovadoras entre los distintos niveles de enseñanza.
En su momento, esta iniciativa se enmarcó dentro del plan de innovación docente de la Universidad, pero atendiendo a su proyección dio como resultado, al curso siguiente, la puesta en marcha de la convocatoria Ósmosis, “con la idea de que fueran los propios centros quienes, de forma activa, demandaran a la UMH ayuda para desarrollar proyectos innovadores, explicando sus necesidades y la forma en la que la Universidad podía colaborar con ellos”, añade la vicerrectora adjunta. Este año se ha celebrado la segunda edición del Programa y ha contado con la participación de un total de 44 centros de Primaria y Secundaria de la provincia de Alicante y Murcia, repartidos en 19 localidades. En estos proyectos colaboran 46 profesores de 21 departamentos diferentes de la UMH.
Según explica Martínez Mayoral, los centros que primero reaccionaron fueron, por una parte, los colegios de Elche, muchos de ellos familiarizados con la UMH gracias a las diferentes iniciativas que se llevan a cabo anualmente como, por ejemplo, la Feria de la Ciencia y la Tecnología de Elche (FECITELX). Por otra parte, se sumaron centros que ya habían trabajado en proyectos puntuales y a través de iniciativas particulares con profesorado universitario. “En este punto tuvo una relevancia especial el Grado en Bellas Artes, donde el profesorado ya había participado en proyectos conjuntos con colegios, de manera que el vínculo ya estaba creado y tan solo era cuestión de integrarlo en la convocatoria”, recuerda la vicerrectora adjunta.
En el diseño de los objetivos del Programa se tuvieron en cuenta las directrices que marca la Comunidad Europea, los retos y las tendencias que se definen a nivel global en el ámbito educativo. Es decir, según Martínez Mayoral, los objetivos plasmados en la convocatoria están vinculados a lo que se está demandando en el presente y lo que se requerirá en el futuro. Tendencias y desafíos identificados en el último informe HORIZON, elaborado por el New Media Consortium (NMC) y la EDUCAUSE Learning Initiative (ELI) para Educación Primaria y Secundaria. Entre las líneas de actuación descritas se encuentra el rediseño de los espacios de aprendizaje, el fomento de la creatividad, el aprendizaje colaborativo, el incremento del uso de recursos digitales, la integración de la gamificación o el fomento de actividades relacionadas con el aprendizaje-servicio. En relación con el aprendizaje-servicio, la vicerrectora adjunta señala que a través de esta línea de trabajo se fomenta la capacidad para involucrarse en temas sociales del entorno haciendo partícipes a los estudiantes y profesores. Por ejemplo, uno de los proyectos llevado a cabo en la edición anterior, y que surgió de los propios estudiantes, consistió en la realización de actividades en un centro de cuidados para personas que padecen alzhéimer.
“Se trata de una gran oportunidad para que los profesores universitarios conozcamos las tendencias educativas de estos niveles, porque no podemos estar al margen, ya que precisamente en los colegios e institutos se están llevando a cabo importantes iniciativas, muy innovadoras, que pueden ser un gran ejemplo para la Universidad”, explica Martínez Mayoral. La vicerrectora adjunta también destaca como fin global la idea de limar las fronteras entre los distintos niveles de enseñanza y fomentar la transversalidad entre áreas, tal y como se puede apreciar en estos tres ejemplos.
 Vicerrectora adjunta de Investigación e Innovación para la Innovación Tecnológica
Vicerrectora adjunta de Investigación e Innovación para la Innovación Tecnológica
La segunda edición ha contado con la participación de 44 centros de enseñanza
Como explica el profesor del Área de Pintura de la UMH Iván Albalate, desde el Grado en Bellas Artes se ha aprovechado al máximo la iniciativa Ósmosis a través de multitud de proyectos. De hecho, Albalate, junto con otros profesores de la UMH como José Antonio Hinojos, José Vicente Martín, Patricia Escario y Miguel Lorente, ha desarrollado intervenciones artísticas en los centros de Altea, además de en otros colegios de la provincia.
Por ejemplo, el proyecto “Siluetas” se llevó a cabo en el CEIP Blanquinal de Altea y consistió en la realización de cuatro murales, en los que se plasmó una composición de multitud de siluetas pintadas por cada uno de los alumnos y tutores del centro. El cuarto y mayor de los murales conformó la unión de todas las siluetas siguiendo el espectro electromagnético que se puede apreciar en el círculo cromático, como explica Iván Albalate. El proyecto se desarrolló durante seis meses e incluyó la visita de los menores a las instalaciones del campus de Altea. Asimismo, en el ámbito del teatro, el Grado también participó con este centro en la elaboración de los decorados del musical “La Bella i La Bèstia”, representado por más de 250 alumnos en el Palau de Altea.
Por otra parte, en el proyecto diseñado durante la XXIII Semana Cultural del CEIP Garganes de Altea, se plasmó también un mural, en esta ocasión con el siguiente mensaje: “Les diferències ens enriquixen, el respecte ens unix”. Una frase, generada por más de 400 alumnos que pintaron el fondo cromático que subyace como cuerpo de las palabras y que pretende ser un recordatorio de los valores del centro por su actual diversidad social y cultural.


Otra de las actuaciones que ilustran la simbiosis existente entre el Grado en Bellas Artes y los centros de enseñanza se llevó a cabo en el municipio de Lorcha, situado en el norte de la provincia de Alicante. En esta ocasión, 20 alumnos elaboraron diversas obras durante un

fin de semana, en una actuación que integró a diferentes centros del Condado de Cocentaina. Por ejemplo, se diseñó un mural con un tema propio de la idiosincrasia de la zona, que fueron las Rondallas.
“Tanto para nuestros propios alumnos, como para los estudiantes de los colegios han sido experiencias muy positivas, que no se suelen adquirir en el transcurrir docente diario pero que resultan muy gratificantes tanto en términos de aprendizaje como colaborativos”, explica el profesor. Estas, además de otras intervenciones artísticas desarrolladas bajo el Programa Ósmosis, son una muestra de las posibilidades de colaboración existentes no solo en beneficio de los diferentes niveles de enseñanza, sino también de la sociedad y de la cultura e idiosincrasia del entorno.
Elproyecto se desarrolló entre el Grado en Comunicación Audiovisual y el de Ciencias Ambientales de la UMH, con la representación de las profesoras Montserrat Jurado Martín y Juana Botía Aranda, respectivamente; junto con el alumnado de Geografía de 3º de la ESO del IES Ifach de Calpe, bajo la coordinación de la profesora Ángeles Fernández. Con el objetivo de mostrar la utilidad de la asignatura de Geografía y aprovechando herramientas digitales de acceso libre, la actividad que se llevó a cabo consistió en crear contenido multimedia en forma de mapas ilustrativos, a través de la plataforma ArcGIS. Una herramienta que pone a disposición de los usuarios contenidos entre los que se incluyen mapas a los que es posible implementar información e imágenes que se adaptan a las necesidades de cada proyecto.
Los estudiantes, de manera colectiva, combinaron mapas digitales con texto, imágenes y otro tipo de contenido multimedia. Como resultado, se crearon diversos mapas con información geográfica de interés sobre, por ejemplo, los parajes naturales protegidos o las zonas españolas afectadas por los últimos incendios. De esta forma, la información recogida en esta aplicación queda a disposición de

los usuarios en sus futuros viajes por España. El proyecto también consistía en crear otros contenidos complementarios como un juego de pasapalabra sobre la tectónica de placas o comparar los ríos y la vegetación de diferentes comunidades autónomas.

A lo largo de la iniciativa, un grupo de estudiantes del IES Ifach visitó la UMH y asistió a un taller con la colaboración de alumnado de Comunicación Audiovisual sobre edición de vídeo e imagen. Según explica la profesora Montserrat Jurado Martín, los estudiantes se mostraron ávidos de conocimiento y muy entusiasmados tanto con la visita a los platós de televisión y de radio del campus, como a los laboratorios de Ciencias Ambientales. El trabajo y el esfuerzo dedicados a la consecución del proyecto le ha valido al alumnado de 3º de ESO B y C del IES Ifach y a su profesora Ángeles Fernández un puesto como finalista en los Premios Nacionales de Innovación Educativa, en la categoría “Uso de tecnología”.

En esta ocasión, la Escuela Politécnica Superior de Elche (EPSE) colaboró con el Centro de Formación de Personas Adultas (CFPA) Mercé Rodoreda de Elche, galardonado con el premio Miguel Hernández del Ministerio de Educación por abordar nuevos modos de actuación para adaptar la formación a las necesidades de los alumnos y a la sociedad del conocimiento. Como explica el profesor de Ingeniería Mecánica de la UMH Ramón Peral, la colaboración se centró en trabajar con el Museo de la Ciencia y la Tecnología (MuCyT) del Centro, iniciativa del profesor de Secundaria José Tomás Pastor Pérez, que constituye un gran ejemplo de modelo de enseñanza-aprendizaje y ofrece un espacio en el que los alumnos pueden aprender a partir de la interacción con las piezas que ellos mismos crean. En las actividades llevadas a cabo participaron tanto profesores y alumnos de la EPSE, como profesorado y alumnado del propio Centro y la coordinación corrió a cargo, también en esta ocasión, del
profesor de la asignatura de Tecnología José Tomás Pastor Pérez, quien estableció que la mejor forma de permitir que sus estudiantes accedieran a conceptos de física y de tecnología avanzados era a través del diseño y elaboración de pequeñas maquetas donde se pudieran poner en práctica conceptos físicos o tecnológicos.
La colaboración inicial de la UMH en este sentido consistió en apoyar el desarrollo de estas maquetas para que fueran más robustas. Fueron los propios estudiantes de la EPSE quienes acudieron al Museo para ayudar a José Pastor en la ejecución de los prototipos, por ejemplo, a través de herramientas de fabricación e incorporando piezas más complejas. Se introdujo tecnología audiovisual con la participación de estudiantes de Electrónica y se apoyó la construcción de una estación meteorológica en una de las maquetas, con la colaboración de un estudiante de Ingeniería Industrial.
Ramón Peral expone que como la experiencia fue muy satisfactoria, se solicitó un segundo proyecto que dio continuidad al primero. En esta segunda fase, se asoció a cada una de las 40 maquetas un código QR que permitía consultar, a través del teléfono, la explicación y funcionamiento de cada maqueta, contenida en una pequeña píldora informativa. Asimismo, en una tercera fase de colaboración, actualmente en desarrollo, se pretende que una selección de los trabajos pueda exponerse en otros centros, creando así una muestra itinerante a través de una versión 2.0 del Museo. Para ello, se está trabajando con una selección de 10 maquetas para mejorar todavía más la robustez de los materiales. Asimismo, las piezas que se han constituido como museo itinerante han estado expuestas este año en la I Feria de la Ciencia InterCEPA de Madrid y en FECITELX 2018.
Tal y como subraya Ramón Peral, a través de esta experiencia se han enriquecido tanto los estudiantes de la UMH que han colaborado, quienes se mostraron en todo momento muy motivados con la iniciativa, como el propio Centro, ya consolidado como un emblema de innovación docente y mejora educativa.

El Parque Científico promueve la relación entre ciencia, tecnología y empresa, así como la generación de un horizonte laboral y empresarial para los titulados de la Universidad. También, según afirma la directora-gerente, el entorno empresarial creado ha conseguido atraer a empresas de fuera de la provincia, interesadas ahora en desarrollar sus proyectos de innovación en el Parque Científico y contactar con investigadores de la UMH. “En definitiva, hemos generado un ecosistema en el que somos capaces de retener el talento de nuestra zona y repatriar el talento que había salido de nuestro país para que vuelva a nuestra tierra”, afirma Tonia Salinas.
Para conseguir sus objetivos, la institución ha establecido dos líneas de actuación principales. Por una parte, la de convertirse en la fuerza motor que promueva la constitución de nuevas empresas capaces de dar solución con sus innovaciones a las demandas del mercado y la sociedad. Por otra, la de contribuir a que las empresas ya creadas puedan seguir creciendo y convertirse en compañías consolidadas, referentes en sus respectivos sectores.
Impulso al emprendimiento
el Parque Científico. Esta red de aceleradoras pública de la provincia de Alicante, creada en 2016, busca ayudar a ayuntamientos e instituciones a fomentar políticas de aceleración emprendedora y a mejorar la competitividad de las empresas de sus municipios.
El Parque Científico de la Universidad Miguel Hernández (UMH) de Elche es un espacio en el que conviven empresas innovadoras que promueven la transferencia de conocimiento entre la Universidad y su entorno, así como start-ups focalizadas en el desarrollo de diversos sectores. Una década después de su nacimiento, la directora gerente del Parque Científico, Tonia Salinas, afirma que el balance es muy positivo: “Contamos con cerca de 80 empresas adheridas que han obtenido dos millones y medio de euros de financiación, aproximadamente, gracias a nuestra ayuda. Hemos impulsado la creación de unas 130 empresas innovadoras y alrededor de 300 puestos de trabajo de alta cualificación”.
Uno de los objetivos fundamentales del Parque Científico es el de canalizar la transferencia de conocimiento y tecnologías de la UMH hasta la sociedad pero, también, el de impulsar la innovación de los propios estudiantes y emprendedores. Con este propósito nació en el año 2012 el Área de Emprendimiento del Parque Científico de UMH, desde donde se coordinan los programas Maratón y Sprint de Creación de Empresas UMH, así como la edición local del programa internacional para emprendedores “Santander Explorer Jóvenes con Ideas”. Estos programas ofrecen a los emprendedores asesoramiento, formación y financiación para poner en marcha iniciativas empresariales innovadoras. Desde su creación, esta Área ha asesorado a más de 700 proyectos, impulsados por cerca de 1.300 emprendedores, y se ha invertido más de 5.000 horas entre sesiones de formación y asesoramiento.
Y por si fuera poco, entre todas sus ediciones, los programas propios Maratón y Sprint de Creación de Empresas UMH han entregado cerca de 600.000 euros en financiación para la puesta en marcha de las iniciativas más innovadoras. Pero, además de este apoyo económico, los proyectos ganadores obtienen otro premio igual de valioso: su incorporación a la red de empresas del Parque Científico de la UMH, dotado de infraestructuras altamente equipadas y servicios empresariales especializados.

Sin embargo, no son sólo los emprendedores de la UMH quienes se benefician de este asesoramiento, sino que también lo hacen los ciudadanos de las localidades vinculadas al programa Emprende UMH. Se trata de una iniciativa de la UMH, gestionada por
Emprende UMH cuenta en la actualidad con dos sedes en la provincia de Alicante: Aspe, que actualmente celebra su 3ª edición, y Castalla, que este año ha iniciado la segunda edición de este programa. Los inscritos, ya sean empresas ya constituidas o proyectos emprendedores, reciben asesoramiento, formación y apoyo integral por parte de técnicos del Parque Científico de la UMH y del agente de innovación de confianza, que se encarga de atender las necesidades de cada municipio. Además, al finalizar el programa, las mejores iniciativas se reparten 1.200 euros de premio para el impulso de sus negocios.
Nuevas sedes
Las instalaciones del Parque Científico en el campus de Elche de la UMH se encuentran casi al 100% de su ocupación. Por este motivo, explica Tonia Salinas, los planes de expansión que se plantea la entidad son ambiciosos. Esta ampliación abarca desde su participación en el desarrollo del proyecto Elche Campus Tecnológico, hasta la creación de nuevas sedes del Parque Científico de la UMH, primero en el campus de Orihuela con la especialización en Agrotecnología y, más adelante, en Sant Joan d´Alacant, enfocada a la Salud.
Por lo tanto, en la actualidad, el Parque se encuentra inmerso en la puesta en marcha de la sede en el campus de Orihuela Desamparados: el Parque Científico AGROTECH de la UMH. En este, se busca crear un polo de desarrollo y dar salida al gran potencial de los investigadores de Orihuela, especializados en el ámbito agroalimentario, agroambiental y agrotecnológico. Posteriormente, se replicará la iniciativa en el campus de Sant Joan d’Alacant, donde se pretende contribuir al futuro de la medicina a través de la creación de empresas basadas en las tecnologías

la entidad alberga empresas innovadoras que apuestan por la tecnología y el desarrollo de conocimiento
Tonia Salinas: “Hemos impulsado la creación de alrededor de 300 puestos de trabajo de alta cualificación”
para la salud y en los nuevos procedimientos para este sector. Sin olvidar, el proyecto para la creación del parque tecnológico en el Parque Empresarial de Elche, un proyecto conjunto con el que la UMH colaborará con el Ayuntamiento de la localidad.
Parque Científico AGROTECH de la UMH
El Consejo de Gobierno de la UMH ha aprobado la puesta en marcha del Parque Científico AGROTECH de la UMH, una sede del Parque Científico de la Universidad que busca aprovechar la potencialidad de los investigadores de la Escuela Politécnica Superior de Orihuela (EPSO). En este campus de Orihuela de la UMH, especializado en el sector de la agrotecnología, trabajan 64 investigadores, integrados en 13 grupos de investigación, que darán soporte y soluciones a la problemática del sector agroalimentario y agroambiental del eje del sureste del Mediterráneo, al ser el único centro que reúne estas características.
El objetivo de la sede AGROTECH del Parque Científico de la UMH es impulsar iniciativas formativas e innovadoras, así como el desarrollo y la transferencia de la investigación en el ámbito agroalimentario y agroambiental. La implantación de AGROTECH está relacionada con la importancia del sector agroalimentario en la actividad económica española. Por este motivo, la UMH cree necesaria la puesta en valor de los conocimientos y las tecnologías generadas en la EPSO para el impulso de este sector económico, la investigación y, especialmente, la transferencia e innovación. De forma complementaria,

la producción sostenible y la atenuación y adaptación al cambio climático, junto a los crecientes requerimientos europeos, sitúan los aspectos agroambientales como una clara oportunidad de empleabilidad, innovación y creación de un nuevo sector económico.
La sede del Parque Científico de la UMH en Orihuela se configura, por lo tanto, como el entorno ideal para la intersección de la actividad de los grupos de investigación de la EPSO, las empresas del sector agroalimentario y de la administración pública. La EPSO está orientada hacia estos retos gracias a los grupos de investigación que se ubican en este campus y que, de forma conjunta, representan un claro exponente de excelencia a nivel estatal e internacional en cuanto a sus indicadores y captación de recursos.
Los objetivos que persigue la creación de esta nueva sede coinciden con una de las principales metas del Parque Científico de la UMH, que no es otra que la de mejorar el tejido empresarial de la provincia. Esto lo consigue impulsando la creación de nuevas empresas y fomentando el contacto entre las empresas del entorno del Parque con los grupos de investigación de la UMH. Tras diez años de experiencia y trabajo, Tonia Salinas subraya que el ecosistema del Parque Científico de la UMH está dando sus frutos y espera que en los próximos 10 años puedan superar las expectativas presentes y alcanzar las óptimas cifras actuales para las sedes de Orihuela y Sant Joan d’Alacant.
Tras años de experiencia en la síntesis de moléculas, los profesionales y fundadores de la spin-off del Parque Científico de la Universidad Miguel Hernández (UMH) de Elche Anfechem centran sus esfuerzos en la creación de moléculas orgánicas. El objetivo es que estas puedan ser empleadas en experimentos físicos, químicos, bioquímicos o biológicos.

Principalmente, Anfechem se encuadra en el sector químico como empresa dedicada al desarrollo, la producción y venta de moléculas orgánicas y polímeros con propiedades optoelectrónicas mejoradas.
Estos compuestos tienen diversas aplicaciones entre las que se encuentran, por ejemplo, la nanotecnología, la producción de energías renovables o la medicina, tanto diagnóstica como terapéutica. En la actualidad, el desarrollo de este tipo de moléculas es un sector en auge a causa de las crecientes necesidades energéticas y el desarrollo de nuevas tecnologías.
Tras la constitución de la empresa y su salida a mercado, Anfechem se ha propuesto ampliar su catálogo de moléculas, buscando siempre una relación entre la calidad, el precio y un servicio adaptado a las necesidades de cada cliente. Anfechem surgió tras ser uno de los proyectos ganadores de la 6ª edición de la Maratón de Creación de Empresas UMH, el programa para emprendedores del Parque Científico de la UMH.
Viajar es, entre otras cosas, un momento para descubrir y divertirse, en el que a veces hay sorpresas de última hora que pueden suponer problemas de organización y estrés. En este sentido, la start-up del Parque Científico de la Universidad Miguel Hernández (UMH) de Elche Travelest, encabezada por Alejandro Linde, Alejandro López y Vladimir Strilets, pretende ofrecer una solución práctica y accesible para evitar inconvenientes durante los viajes.
Travelest es una aplicación móvil que proporciona la mejor manera de organizar una ruta turística urbana, gracias al algoritmo de inteligencia artificial desarrollado por el equipo promotor. En función de los parámetros especificados, calcula una ruta que optimiza el número de lugares visitados con el fin de mejorar la experiencia turística en una ciudad. El trayecto se ajusta al tiempo del que el usuario dispone para la visita, sus preferencias y el lugar de inicio y fin de la ruta.

El proyecto nace tras ser una de las ideas ganadoras de la 5ª edición del Sprint de Creación de Empresas, el programa para emprendedores del Parque Científico de la UMH. También fueron galardonados en el concurso internacional Plataforma Talento, impulsado por Volkswagen y EL PAÍS, y con el premio internacional Treelogic 2017 al Espíritu Innovador.
En la actualidad, trabajan en el lanzamiento de la app, que estará disponible en las próximas semanas: aunque inicialmente está previsto su testeo en varias localidades de la provincia de Alicante, esperan poder ampliar pronto el ámbito territorial en el que Travelest ofrezca rutas optimizadas para los viajeros.

Travelest, innovando en el modo de viajar
La futura sede en el campus de Orihuela se configura como la intersección ideal entre la UMH y las empresas agroalimentarias del entornoImágenes Parque Científico UMH

Desde la prehistoria, el ser humano ha utilizado materiales de su entorno para crear instrumentos que facilitaran su subsistencia. En la actualidad, los implantes dentales o las prótesis quirúrgicas utilizadas en traumatología o cirugía maxilofacial tienen en común la utilización de biomateriales capaces de transformarse en tejido óseo neoformado, en aras de mejorar la calidad de vida de los pacientes.
Durante las últimas dos décadas, la investigadora del Instituto de Bioingeniería de la Universidad Miguel Hernández (UMH) de Elche Piedad N. de Aza Moya dirige el grupo de Ciencia de Materiales, donde se ha llevado a cabo una serie de proyectos de investigación consistentes en la aplicación de los diagramas de equilibrio al diseño, síntesis y procesado de materiales cerámicos para aplicaciones en el campo de los biomateriales. Las investigaciones actuales de la profesora de la UMH se centran en el estudio de nuevos materiales capaces de estimular activamente la regeneración y la reparación de tejido óseo dañado, de forma que puedan restablecer su función.
Pregunta. ¿Qué es un biomaterial y de qué modo se emplean?
Respuesta: Un biomaterial es cualquier material que no provoca reacciones adversas en nuestro organismo cuando éste entra en contacto con él. En cuanto a su uso, desde que los investigadores se dieron cuenta de que existía una aceptación por parte del organismo hacia este tipo de materiales, se han hallado aplicaciones muy diversas con el objetivo de mejorar la calidad de vida del paciente.
¿Cuál es el primer registro del uso de biomateriales y en qué consistía?
Los biomateriales se llevan utilizando desde la prehistoria, el ejemplo más antiguo es el Hombre de Kenewick que, a pesar de tener una flecha clavada en la cadera, se ha demostrado que podía haber continuado su vida con normalidad. Es el primer hecho en el cual se puede constatar que el ser humano puede convivir con un material no biológico dentro de su cuerpo. Los implantes más utilizados a lo largo de la historia han sido los implantes oculares y las dentaduras, aunque hoy en día son los implantes óseos, debido principalmente a los accidentes de tráfico, accidentes laborales y a una mayor esperanza de vida, que hacen desear a la población no sólo vivir más, sino con una buena calidad.
¿Qué dificultades ha planteado el uso de los biomateriales?
En gran parte, el problema que existía antaño era que se carecía de las técnicas quirúrgicas necesarias para realizar la implantación y su efectividad y salubridad suponían un problema. No es que no hubiera buenos biomateriales, sino que no se sabía cómo mantener a raya las infecciones derivadas de una cirugía. La aparición de técnicas asépticas quirúrgicas, la pasteurización y el descubrimiento de los rayos X fueron avances en medicina que hicieron proliferar la utilización de biomateriales, principalmente metales, con el fin de sustituir el tejido dañado.
¿Cómo ha evolucionado su aplicación a lo largo de la historia?
Durante los últimos dos siglos, encontramos una gran cantidad de ejemplos en los que materiales externos a nuestro organismo se han acabado introduciendo en él y no im-
pedían a los afectados realizar su vida con normalidad. Por ejemplo, los heridos por esquirlas de polimetilmetacrilato, procedentes de las carlingas de los aviones de la Segunda Guerra Mundial, podían llegar a pasar varios días con los restos en su cuerpo, antes de ser atendidos y no perecer.
Gracias al descubrimiento de las compatibilidades entre el cuerpo humano y estos biomateriales aparece la primera generación de biomateriales, cuyo único fin era reemplazar el tejido. Hoy día, ya entrados en el siglo XXI, el principal objetivo ya no es sustituir o reemplazar el tejido dañado sino regenerarlo mediante ingeniería de tejidos, adentrándonos así en los materiales de tercera generación. En aquel entonces, las prótesis se solían realizar con metales nobles como el oro o la plata, que servían como sustitutos de elementos óseos perdidos por los heridos o enfermos. En la actualidad, tenemos no solo metales, sino cerámicas, polímeros y materiales compuestos, como sustitutos de todo tipo de tejidos dentro del organismo.
Durante la segunda generación de biomateriales se intenta reparar los tejidos, por lo que se busca materiales que reaccionen químicamente con el mismo y con la tercera generación de biomateriales se busca, además de que los materiales sean biocompatibles, que sean bioactivos y biodegradables para poder ser reemplazados por tejido nuevo y así regenerarlos mediante técnicas avanzadas de ingeniería de tejidos, combinando los biomateriales con células como pueden ser las células madre. Algunos de estos materiales son las llamadas biocerámicas de fosfatos cálcicos, capaces de favorecer la regeneración de tejido óseo y que poseen una alta biodegradabilidad.
¿Cuáles son los biomateriales más utilizados? Los materiales pueden ser metálicos, cerámicos, poliméricos o compuestos, tanto densos como porosos. Nosotros trabajamos actualmente con materiales cerámicos porosos, ya que lo que buscamos es fabricar un andamio que sea colonizado por células de un paciente para luego al ser implantado pueda regenerar el tejido óseo dañado y que desaparezca, después de que haya cumplido su función. Para ello, empleamos una serie de estructuras porosas hechas a base de cerámicas biodegradables y bioactivas que facilitan la unión a en términos celulares cuando el tejido óseo se está regenerando de una lesión.
Piedad N. de Aza MoyaInvestigadora del Instituto de Bioingeniería UMH“Empleamos la respuesta biológica del organismo hacia un daño tisular, junto con soportes sintéticos diseñados sobre principios de ingeniería”
Imagen A: Un andamio ceramico realizado en el laboratorio a partir de materiales de tercera generacion.
Imagen B: Andamio ya colonizado por celulas listo para ser implantado y utilizado en ingenieria de tejidos.

Vicente Galiano, profesor de Ingeniería de Tecnologías de la Información de la UMH

¿Cómo se lleva a cabo la investigación de estas cerámicas?
Las primeras biocerámicas fueron desarrolladas e introducidas en el mercado entre los años 70 y 80 y consistían en fosfatos de calcio, como son la hidroxiapatita y el fosfato tricálcico o mezclas de ambos. Se trata de biomateriales de primera y/o segunda generación destinados a reemplazar el tejido, es decir, actuar como relleno del defecto óseo. Aunque algunos de estos materiales son bioactivos (segunda generación) tienen el inconveniente de que no son totalmente reabsorbidos. La hidroxiapatita no se degrada totalmente aún después de varios años, el fosfato tricálcico es mucho más biodegradable pero aún después de 1 ó 2 años se pueden encontrar restos, al igual que ocurre con los vidrios bioactivos. Finalmente, con la excepción de los vidrios bioactivos, estos materiales carecen de capacidad de estimular la osteogénesis, es decir, el proceso a través del cual ocurre la formación del tejido óseo.

¿En qué consiste el concepto básico de ingeniería de tejidos?
En emplear la respuesta biológica natural del organismo hacia un daño tisular, conjuntamente con soportes sintéticos diseñados sobre la base de principios de ingeniería. Desde el punto de vista biológico, en la ingeniería de tejidos aplicada a la regeneración ósea están implicadas células, matriz extracelular, comunicaciones intercelulares, interacciones célula-matriz y factores de crecimiento. El hueso posee una configuración tridimensional, pero las células normalmente no crecen en una disposición tridimensional por sí mismas. Para lograrlo, es necesario ofrecerles un soporte tridimensional con estructura similar al hueso. Este soporte tridimensional, andamios
o granulados, debe poseer determinadas propiedades para desempeñar exitosamente su función.
¿Cuántas personas participan en las labores de la investigación de biomateriales dentro del Instituto de Bioingeniería?
Pablo Velasquez y yo somos investigadores el Instituto de Bioingeniería y Ángel Murciano y Patricia Mazón son investigadores del Departamento de Ciencia de Materiales, Óptica y Tecnología Electrónica. Aunque trabajamos conjuntamente en la línea de biomateriales, cada uno tiene un enfoque distinto, que a su vez resulta complementario para poder desarrollar nuevas biocerámicas.
Por un lado, Ángel Murciano es especialista en la síntesis de materiales mediante la técnica de sol-gel; Patricia Mazón, mediante reacción en estado sólido y Pablo Velásquez es un especialista en técnicas de análisis superficial de materiales. Todos colaboramos en los diferentes estudios in vitro y en la caracteriza-
ción de los biomateriales, comprobando sus propiedades físico-químicas y mineralógicas antes de los estudios biológicos. Finalmente, después de la implantación, realizamos el estudio post mortem de los mismos.

¿Hacia dónde se dirigen sus investigaciones?
Nuestro trabajo va desde el diseño de nuevas composiciones, síntesis y procesado de nuevas biocerámicas, hasta los estudios biológicos in vitro e in vivo, que realizamos con nuestros colaboradores externos. Nuestra línea de investigación actual abarca el diseño, preparación, caracterización y estudio in vitro e in vivo de biomateriales, en forma de granulados, cementos o andamiajes, con elevada macroporosidad interconectada, que permitan el ajuste de la tasa de biorreabsorbibilidad y de liberación de fármacos incluidos en los materiales, con objeto de mejorar su capacidad osteoinductiva y/o angiogénica. De esta forma, nuestra meta es ser capaces de ofrecer biomateriales adaptados a las necesidades de cada usuario.
Los supercomputadores son ordenadores de altas prestaciones, capaces de realizar tareas de cálculo a una velocidad sorprendente. Así como medimos la velocidad de los coches en Km/hora, la velocidad de los ordenadores se mide en FLOPS, es decir, Operaciones de Coma Flotante por Segundo. Y aunque nos parezca que un ordenador de sobremesa con un procesador i7 es rápido, hemos de saber que el supercomputador más potente del mundo es 66 millones de veces más rápido que el nuestro de sobremesa.
Un supercomputador realmente no es un solo elemento, sino un gran número de computadores que trabajan en paralelo para resolver un
problema o simulación de enormes dimensiones. Por ejemplo, el supercomputador más potente actualmente está en China y posee más de 10 millones de procesadores, mientras que el de nuestra casa puede que tenga de 2 a 8 procesadores.
Los supercomputadores se utilizan para resolver problemas muy complejos o de gran tamaño, de disciplinas científicas diversas. Por ejemplo, se utilizan para modelar la dinámica molecular de las proteínas frente a enfermedades como el alzhéimer, la fibrosis quística y muchos tipos de cáncer, realizan simulaciones del cosmos, permiten simular el comportamiento de un tsunami o explosiones nucleares sin necesidad de que ocurran realmente.
Alfonso Ortega Giménez, profesor de Derecho de la UMH

Se hace preciso distinguir entre inmigrantes y refugiados, ya que jurídicamente son diferentes. Un inmigrante es la persona que se desplaza a otro país para establecerse en él. Sin embargo, un refugiado es la persona que huye de situaciones de conflictos armados y/o persecuciones por razones que pueden ser de raza, de religión, de nacionalidad, de pertenencia a un grupo social determinado o de opinión política.
Los refugiados requieren salvaguardas legales específicas como la supresión de cualquier proceso de devolución, expulsión o extradición que pese sobre ellos. Además, tienen derecho a la asistencia jurídica gratuita
e intérprete, a la atención sanitaria, a ser documentados como solicitantes de protección internacional y a recibir las prestaciones sociales en los términos que recoge la Ley, entre otros. En el mundo se estima que existen unos 42 millones de refugiados.
Inmigrantes y refugiados representan dos realidades distintas, pero comparten un objetivo común: emprender una nueva vida en un lugar mejor. No obstante, a grandes rasgos, unos huyen por motivos políticos y otros por razones económicas. El problema reside muchas veces en diferenciarlos, sobre todo, cuando el país de origen es un lugar de conflicto y también de problemas económicos.

El Proyecto expositivo Plan Z, promovido por la Facultad de Bellas Artes de la Universidad Miguel Hernández (UMH) de Elche y en el que participa el Ayuntamiento de Altea, tiene como objetivo mostrar la obra de artistas, profesores y estudiantes de escuelas de arte extranjeras con las que colabora la Facultad. Se trata de una iniciativa que forma parte del Plan de Internacionalización, promovido por el Vicerrectorado de Relaciones Internacionales de la UMH y se caracteriza por el hecho de que las obras exhibidas, en las que cobra protagonismo el concepto de proyecto, cuentan con un soporte replicable a partir de formatos digitales, de modo que las creaciones no se transportan y pueden montarse incluso sin la presencia del autor. El comisario de las exposiciones ha sido el también decano de la Facultad de Bellas Artes de la UMH, José Vicente Martín Martínez, y el profesor Miguel Lorente Boyer ha sido coordinador del proyecto.
José Vicente Martín Martínez explica el cambio de paradigma que supone en las prácticas artísticas la transición del arte basado en el objeto al arte basado en proyectos y actos de exhibición. José Vicente Martín Martínez ha trabajado con la Galería Buades de Madrid (1992-1997), la Galería La Nave de Valencia (1997-1999) y la Galería Muelle 27 de Madrid (2003-2006) y es miembro del colectivo La Mutua Artística, en cuyo contexto desarrolla proyectos colaborativos e interdisciplinares. Como investigador, ha estudiado los antecedentes del arte moderno en el contexto de la relación entre romanticismo y vanguardia. En los últimos años, se ha dedicado al estudio de los dispositivos ópticos pre-fotográficos y de las relaciones entre la imagen analógica y digital, sobre los que se basa su trabajo artístico actual.
El proyecto Plan Z contempla obras que representan la transición del arte basado en el objeto al arte basado en el proyecto y actos de exhibición ¿Por qué esta transición supone un cambio de paradigma en las prácticas artísticas?
La socióloga francesa especialista en arte Nathalie Heinich propone la transición del arte basado en el objeto al arte basado en el proyecto como un cambio de paradigma e incluso pone ejemplos de cómo ambas tendencias perviven. Desde los orígenes del arte moderno, con el inicio del romanticismo y el realismo (principios del siglo XIX), se empieza a otorgar protagonismo a los elementos que forman parte del proceso. Y esa dialéctica entre el proceso, proyecto y objeto se desarrolla a lo largo de toda la transición entre el arte moderno y el arte contemporáneo. Con la llegada del concepto de “serie” y la capacidad de reproducción de las obras, se ha ido abandonando el objeto y ahora predomina el concepto de proyecto. En este tipo de prácticas artísticas lo importante ya no es que el arte se materialice de una manera determinada, ya sea mediante fotografía, video, pintura... Sino que haya una idea o historia bien definida.
Por ejemplo...
Cuando explico el concepto de la teoría narrativa en el Máster Universitario en Proyecto e Investigación en Arte hago hincapié en la diferencia entre discurso e historia. La historia es el marco de todos los acontecimientos que pueden ocurrir y el discurso es su concreción. Por ejemplo, en la saga de La guerra de las galaxias, la historia es todo lo que ocurre en ese universo ficcional, mientras que el discurso puede ser un cómic, una película, el libro... Y esa relación entre historia y discurso es la que se da entre la historia y la materialización del proyecto. De hecho, el proyecto tiene que ser definido en términos de relato. Por ello, cada vez se exige más a los estudiantes y artistas que definan la obra en términos de su explicación conceptual o discursiva, que es lo que hace las veces de historia, de marco general, pero luego su concreción en un objeto artístico o en otro ya no es tan importante, sino que lo relevante es que la historia esté bien definida. El discurso puede ser uno u otro, pero el relato, el marco conceptual, es lo fundamental.

¿Cambia este protagonismo de la historia el peso de la autoría, de la firma?
Lo que ocurre es que se percibe el paso de la importancia de que el objeto esté hecho por la mano del artista, autógrafo, a que no necesite estar hecho por él. Y esto nos lleva a todas aquellas obras que están concebidas por un autor pero luego materializadas por artesanos o asistentes. Y eso no les quita valor, no es importante que la obra haya hecho físicamente el artista. Además, se aprecia la importancia del formato digital que precisamente lo que permite es la replicación y diluye el concepto de original. Y esta capacidad de diluir la obra y de convertirla en algo polimorfo necesita que se concrete, que se fragüe en un acto de exhibición. Porque la exhibición es aquello que, en cierta manera, le da existencia.
De ahí la suma importancia de la concreción de las instrucciones de creación de la obra en el catálogo. Sí, y esta idea está conectada con la reproducción digital y es algo que se percibe en todas las obras que se han exhibido dentro del Proyecto Plan Z. No ha sido necesario que la obra fuera transportada, por el contrario, lo que se envía son las instrucciones o una réplica en digital que permite reproducirla. De manera que ni siquiera es necesario contar con la presencia del autor. No obstante, en el caso de los artistas invitados bajo el paraguas del Plan Z, sí que pudimos contar con su presencia en la Facultad, en la que ofrecieron talleres y sesiones que enriquecieron a nuestros estudiantes. Esto fue gracias a las ayudas del Vicerrectorado, pero las exposiciones hubieran podido desarrollarse igualmente sin la presencia de los artistas, a partir de sus indicaciones, precisamente por tratarse de obras basadas en el proyecto y en las características propias de este tipo de trabajos
expositivos. De hecho, algunas de las obras expuestas fueron adaptaciones de obras anteriores de los autores, acondicionadas a un soporte u otro, a un entorno u otro.
¿Son las obras las que se adaptan al entorno?
Antes, el concepto de diseño expositivo consistía en que el espacio se acondicionaba a los objetos, pero ahora es totalmente al contrario. Es el objeto el que se adapta al espacio expositivo. Y se aprecia un predominio de las instalaciones, que hasta el momento eran un subgénero de la escultura, pero han cobrado un gran peso en el panorama artístico contemporáneo. Todas estas características propias del arte basado en proyectos han confluido de una manera exitosa en el arte contemporáneo. Los instrumentos de legitimación del arte actual, es decir, las galerías, las bienales, los museos, premios, etc. están reconociendo obras que tienen esa idea de proyecto y exhibición.
Se percibe también el predominio de diferentes técnicas y medios en la misma obra.
Es otra de las características propias del devenir del arte contemporáneo y es un tipo de formación en la que hacemos mucho hincapié entre nuestros alumnos: que sean capaces de enunciar el mismo concepto con distintos recursos medios o técnicas. La formación ahora está dirigida, porque así lo demanda el contexto, a que el futuro artista tenga capacidad de formular el relato en discurso y medios distintos.
El Proyecto Plan Z se plantea como un trabajo abierto. ¿Habrá por tanto un catálogo 2018/2019 que recoja de nuevo las obras de los artistas internacionales que colaboren con la Facultad? Esa es nuestra intención, darle continuidad a este proyecto, porque ha resultado muy enriquecedor para ambas partes, tanto para los propios artistas invitados como, sobre todo, para nuestros alumnos. Lo cierto es que el proyecto ha conllevado un gran esfuerzo y ahora nuestra intención es mantenerlo, incorporando a otros compañeros y dándole continuidad. Son muchas las acciones derivadas de la iniciativa, desde conferencias, que aparte se grabaron y están a disposición del alumnado, como talleres y exhibiciones. No hay duda de que por parte de la Facultad se ha obtenido un gran provecho de la iniciativa, una experiencia muy enriquecedora que ha recompensado el importante esfuerzo empleado.
La iniciativa tiene como objetivo mostrar la obra de artistas extranjeros que colaboran con la Facultad de Bellas Artes de la UMH
Se invitó a los autores a generar sus exposiciones mediante archivos digitales e instrucciones remitidas por internetJosé Vicente Martín Martínez Comisario de las exposiciones del proyecto Decano de la Facultad de Bellas Artes UMH . Alicia de Lara
A través de la capacidad de réplica, proyección e interpretación del arte contemporáneo y de su simbiosis con las nuevas tecnologías, se invitó a los artistas a generar sus exposiciones mediante archivos digitales e instrucciones remitidas por internet. Las obras, con características distintas entre sí tanto formal como conceptualmente, fueron exhibidas en en la Sala EspaciØ del Palau Altea y han quedado recogidas en el catálogo del proyecto expositivo PLAN Z 2016/2017. Los artistas colaboradores fueron: Daniel Laskarin, Simon Lewandowski, Carl-Erik Engqvist, el grupo brook & black, Emily Hermant y Micael Norberg.


Laskarin investiga las formas en las que el arte puede proporcionar experiencia sensorial al pensamiento, creando un puente entre la sustancia y lo que no puede describirse con palabras. Entre los diversos medios que utiliza se encuentra la fotografía, el vídeo, la óptica, los sistemas robóticos, las instalaciones y el sonido. Ha trabajado en el diseño de escenografía, proyecciones en espacios públicos y encargos a gran escala.

www.laskarin.ca

Lewandowski es codirector de Wild Pansy Press, un grupo de artistas que trabaja de modo colaborativo con sedes en Leeds y Londres. Son comisarios, editores y creadores de obras experimentales que utilizan las prácticas de la lectura, escritura y publicación como su medio y/o contenido. Además, es profesor en la Escuela de Bellas Artes, Historia del Arte y Estudios Culturales de la Universidad de Leeds, donde también desempeña el cargo de coordinador de Movilidad.

www.lewandowski.lowtech.org
Engqvist es un artista contemporáneo y el director artístico de Humlab, un laboratorio interdisciplinar de humanidades digitales ubicado en Umeå, Suecia. Desde 2006, ha trabajado activamente con problemas, cuestiones y perspectivas relacionadas con la inteligencia artificial, la robótica, la nanotecnología, la biotecnología, los videojuegos y los mundos virtuales. Actualmente, se encuentra inmerso en múltiples proyectos para discernir el uso artístico y los riesgos que implica la inteligencia artificial y los algoritmos de aprendizaje profundo.

www.visionaryexistence.com
Enlace a la publicación del catálogo: http://campusaltea. edu.umh.es/wp-content/ uploads/sites/1104/ 2018/04/PLANZ_ digital-.pdf
Hermant es una artista interdisciplinar cuyas esculturas, dibujos e instalaciones a gran escala exploran temas relacionados con la comunicación, el género, el trabajo y las experiencias espaciales del cuerpo. Su trabajo ha sido expuesto ampliamente en museos, galerías y festivales y ha aparecido en multitud de publicaciones. Actualmente, es profesora asistente en la Audain Faculty of Art de la Emily Carr University of Art + Design.
www.emilyhermant.com
brook & black es un grupo de artistas cuyo trabajo se desarrolla mediante un proceso de investigación, diálogo y creación compartidos. Han realizado residencias y encargos para instituciones artísticas internacionales en los que el proceso y las obras resultantes responden a obras históricas específicas provenientes de las colecciones y el contexto de estos mismos museos. Trabajan también en asociación con comunidades vecinales, planificadores y arquitectos para realizar trabajos permanentes y temporales en el ámbito público.
www.axisweb.org/p/brookandblack

Norberg explora su entorno cercano y temas próximos a su persona. Su arte y métodos pueden ser vistos como documentales y a menudo están limitados dentro de un tiempo, espacio y lugar específicos. Su obra se basa en medios audiovisuales, texto y fotografía. Estudió a principios de los años 90 en la Academie of Fine Art de Trondheim, Noruega: en la Koninklijke Academie van Beeldende Kunst en La Haya, Holanda; y la Academy of Fine Arts en Umea, Suecia; y ha expuesto su trabajo desde entonces a nivel nacional e internacional. Como profesor, ha estado enseñando arte contemporáneo en el contexto académico desde 1996.
www.micaelnorberg.com
En las sociedades dominadas por las condiciones modernas de producción, la vida se presenta como una inmensa acumulación de espectáculos. Todo lo que se vivía directamente se ha reducido a una representación.
Uno de los aspectos más positivos del descubrimiento de los antibióticos fue que no solo funcionaban bien una vez, sino otra, otra y otra. Pero desde que Fleming descubrió la penicilina hasta hoy, la efectividad de este tipo de fármacos ha disminuido hasta niveles que preocupan a los expertos. Cuando un antibiótico entra en contacto con una colonia de bacterias, muchas de ellas mueren, pero algunas son capaces de sobrevivir y convertirse en farmacorresistentes. La Organización Mundial de la Salud (OMS) califica el problema de la resistencia a los antibióticos como una de las mayores amenazas y alerta sobre el alcance del problema. Según la Organización, la resistencia a los antibióticos se acelera, sobre todo, con el uso indebido y abusivo de estos fármacos. Pero, además, la entidad subraya las deficiencias en materia de prevención y control de las infecciones.
Con el objetivo de concienciar a la población sobre el problema de la resistencia microbiana a los antibióticos y fomentar entre los jóvenes la vocación por la investigación científica, la Universidad Miguel Hernández (UMH) de Elche se ha unido a Small World Initiative (SWI), una iniciativa docente internacional con enfoque educativo y divulgativo. El investigador del Departamento de Producción Vegetal y Microbiología de la UMH Manuel Sánchez subraya la importancia del doble enfoque de SWI, puesto que, además de formar a los estudiantes universitarios y de institutos, persigue que la población sea más consciente de la problemática de la resistencia a los antibióticos. El
proyecto está dirigido, también, por las investigadoras de la UMH María Francisca Colom y Marina Torreblanca.
Universitarios docentes
Sánchez Angulo explica que, en la primera etapa, los estudiantes buscarán en muestras de suelos microorganismos capaces de producir un antibiótico, para aislarlos y caracterizarlos. De esta forma, los universitarios pondrán en práctica parte del proceso de descubrimiento de un antibiótico. Además, aprenderán técnicas de aislamiento de microorganismos con interés biotecnológico potencial, la preparación de medios de cultivo o el manejo de instrumental técnico. Sánchez Angulo señala que los microorganismos aislados se depositarán en una colección pública para que puedan ser accesibles a otros investigadores científicos.
Durante este proceso formativo, los estudiantes adquirirán, también, habilidades de comunicación para trasladar a sus compañeros su conocimiento y divulgar así el problema de la resistencia a los antibióticos. Sánchez Angulo
cuenta que el profesor de la Universidad Complutense de Madrid Víctor
Cid implantó este proyecto en España durante el curso 2016/17. Y que este profesor, en colaboración con el Grupo de Docencia y Difusión de la Sociedad Española de Microbiología (SEM), consiguió organizar durante el verano de 2017 la red SWI Spain, en la que involucró a varios profesores de Microbiología de diversas universidades españolas, incluida la UMH.

Microorganismos invencibles
El profesor Sánchez Angulo asegura que cada vez hay más infecciones causadas por microorganismos resistentes a los antibióticos. Para el investigador, uno de los aspectos más importantes es concienciar a la sociedad de que los antibióticos son un bien escaso y valioso que se debe cuidar. “Qué mejor mane-
ra que formar a los estudiantes de instituto, para que además de incentivarlos a estudiar carreras científicas, sean capaces de divulgar”, reitera.
Las bacterias evolucionan muy rápido y son capaces de adaptarse a condiciones adversas. La primera causa de mortalidad en España son las enfermedades cardiovasculares, seguidas de las causadas por procesos tumorales, según datos publicados en 2016 por el Instituto Nacional de Estadística. El investigador cuenta que, según la Sociedad Española de Enfermedades Infecciosas y Microbiología Clínica, el número de muertes debidas a las resistencias a los antibióticos asciende a 35.000: “Lo que colocaría esta causa en tercera o cuarta posición”. Por su parte, la Agencia Española del Medicamento (AEMPS) estima en 2.800 las muertes causadas por las resistencias a los antibióticos, “cifra que supera con creces a los 1.200 muertos en accidentes de tráfico”, precisa el docente. La problemática, tal como relata el profesor de la UMH, es compleja y multifactorial. Además de que cada vez se descubren menos antibióticos, también aparecen más resistencias. Las causas principales tienen que ver con el mal uso que se hace de estos fármacos, puesto que la ciudadanía rara vez llega al final del tratamiento. Sánchez Angulo explica que el antibiótico no solo mata a los microorganismos infecciosos: “Si no llegamos al final del tratamiento, favorecemos que aquellos que hayan aguantado puedan extenderse más porque eliminamos a la competencia. Los que sobreviven se convierten en resistentes”.
El profesor de la UMH coordina un programa formativo para que los estudiantes sean capaces de conocer y divulgar la importancia del uso adecuado de los fármacosBelén Pardos
Las bacterias evolucionan muy rápido y son capaces de adaptarse a condiciones adversasDavid vs. Goliath / Víctor J. Cid. Sociedad Española de Microbiología Colonias bacterianas crecidas a partir de una muestra de suelo. Una de ellas parece producir una sustancia que impide el crecimiento de la colonia más grande. Esa sustancia puede ser un posible antibiótico
La importancia del papel de los antibióticos es clara y rotunda. Desde un tratamiento antitumoral hasta una intervención en el dentista necesitan del uso de antibióticos. Sin ellos, hasta el rasguño provocado por una planta en el jardín podría tener consecuencias muy graves. Pero, tal como remarca el investigador, este sería el peor escenario posible ya que se trabaja para mejorar la situación.
La dificultad de crear nuevos fármacos
Unas de las razones principales por las que no se descubren nuevos antibióticos es que su proceso de creación es caro, lento y poco rentable para la industria. Cualquier medicamento que llega a la farmacia ha pasado por un proceso de 10 años para determinar que cura, incluida la fase de ensayos clínicos, y necesita una tecnología para ponerlo en circulación. Las empresas no rentabilizan los antibióticos como lo hacen con otros fármacos como los analgésicos o los antidepresivos.
Por ejemplo, para el profesor se trata de una paradoja, porque cuantos más sistemas de seguridad existen para proteger a la ciudadanía, más caro es el proceso productivo y sólo pueden afrontarlo las grandes compañías.
“Se trata de la ley de la oferta y la demanda, estamos dispuestos a pagar mucho por unas cosas, vemos muy caras otras y quizá no queremos invertir en antibióticos”, asegura Sánchez Angulo.
Además, Sánchez Angulo recalca que dado el problema que existe con las resistencias, la vida útil de los antibióticos es corta y esto también complica el proceso productivo.
“Sin embargo, un analgésico es para toda la vida, será efectivo ahora y siempre”, señala. El investigador insiste en la complejidad del problema, que no se puede simplificar culpabilizando únicamente a las empresas farmacéuticas. En este sentido, el profesor insiste en la importancia de utilizar bien los antibióticos, pero, también, en tomar medidas básicas de higiene como lavarse las manos.
Por otra parte, el uso de los antibióticos en animales también forma parte del problema de la aparición de resistencias. Manuel Sánchez señala que la normativa exige que los antibióticos sólo puedan utilizarse en animales enfermos y bajo control veterinario. Independientemente de que así sea, igual que sucede con seres humanos, cuando se elimina un antibiótico del organismo termina por pasar al medio ambiente a través de las deyecciones y ahí se produce una selección de los microor-
ganismos resistentes. “Por eso, muchas de las bacterias resistentes a los antibióticos se encuentran en hospitales, simplemente porque allí es donde más se necesitan, y lo mismo sucede en las granjas”, asegura Sánchez Angulo. En el mismo sentido, el profesor puntualiza que las aguas que provienen de depuradoras también pueden contener microorganismos resistentes, “precisamente porque tratan todas las aguas residuales de esas granjas y esos hospitales”.

puede ser optimista si todos los implicados en el grave problema: educadores, sociedad, instituciones públicas, científicos, industria… trabajan para mejorar la situación”. Medidas como evitar automedicarse, terminar el tratamiento o que los profesionales sólo receten antibióticos cuando sea estrictamente necesario pueden ayudar a mejorar el problema.
Aunque los controles son restrictivos, por pocas bacterias farmacorresistentes que aparezcan, sobreviven y se diseminan. El profesor puntualiza que aunque las depuradoras eliminan con mucha eficiencia a los microorganismos de las aguas residuales, no se puede asegurar un 100% de eliminación.
El futuro
El microbiólogo explica que el peor escenario posible se daría en el año 2050, si no se tomara ningún tipo de medida para revertir la situación. Pero, a juicio del experto, “el futuro
Pero, además, que los gobiernos e instituciones fomenten campañas de concienciación y vacunación. No sólo es importante la investigación para crear nuevos antibióticos, sino incluso para mejorar las herramientas de diagnóstico, de manera que sean más precisas y se pueda minimizar el uso de los antibióticos. “Los científicos ya estamos haciendo un montón de cosas”, cuenta Sánchez Angulo, pero para todas ellas es imprescindible inversión. Para Manuel Sánchez, la situación, aunque grave, es esperanzadora si se toman las medidas adecuadas. “Nuestro cerebro es el arma más poderosa para luchar contra los microorganismos resistentes a los antibióticos”, asegura.
Lisa y Mario son una niña y un niño que han adquirido superpoderes. Se sienten capaces de hablar en público, están seguros de sí mismos, han desterrado la ansiedad y disfrutan de su día a día. Mejoraron sus habilidades emocionales a través del programa Super
Skills y ahora se dedican a ayudar a otros niños a convertirse también en superhéroes. Les acompañan, a ellos y a sus padres, a través de actividades y juegos para que adquieran “los poderes” necesarios para ser más felices.

Angulo: analgésico“Un es para toda la vida, efectivoseráahora y siempre”
Super Skills es un tratamiento dirigido a niños y niñas entre 8 y 12 años con tendencia a preocuparse demasiado y a sentirse tristes, con problemas de autoestima, timidez o carencias para relacionarse con sus compañeros y compañeras. Tiene origen anglosajón, fue creado por la doctora Cecilia Essau de la Universidad de Roehampton (Reino Unido) y el doctor Thomas Ollendick de la Universidad de Pensilvania (Estados Unidos). En España, los profesores de Psicología de la Salud de la Universidad Miguel Hernández (UMH) de Elche Mireia Orgilés y José Pedro Espada han traducido, adaptado e introducido innovaciones en el programa y están estudiando su eficacia junto con el equipo del grupo de investigación AITANA.


El caso español de Super Skills se encuentra en estos momentos en su segunda edición y está a la cabeza en publicación de resultados respecto a los otros países que lo están aplicando. Tal y como explica Mireia Orgilés, al principio se ofertó a diferentes centros para aplicarlo en grupos pequeños, de 5 menores como máximo, y enfocado a niños que presentaban problemas emocionales. “A pesar de que nuestra idea inicial era aplicarlo a unos 60 niños, en ese primer año se incluyó a 200, gracias a la alta demanda que tuvimos. La participación de los padres fue muy grande. Primero se seleccionó a los más necesitados y luego se terminó aplicando al triple de casos de los previstos”, explica la profesora.
Los niños y niñas que han recibido el tratamiento han mostrado, después de la intervención, una mejor autoestima, mejores habilidades para relacionarse con otras personas, mejor estado de ánimo y más recursos para relajarse y afrontar situaciones que les preocupan. A lo largo de sus 8 sesiones (una por semana y cada una con una duración de entre 45 y 60 minutos, dependiendo de la modalidad), los participantes mejoran sus habilidades para actuar ante otros, aprenden a pensar de manera positiva y a hacer amigos. El programa consta de lecturas, actividades, juegos, role-playing y vídeos que ayudan a los menores a mejorar su estado emocional y, al finalizar cada sesión, la familia recibe un documento explicativo en el que se indican los objetivos trabajados, para que los progenitores estén al tanto de los avances y puedan hacer seguimiento y ayudar a sus hijos. “En cierto modo, formamos también a los padres, porque su labor es imprescindible en todo el proceso, ya que los recursos de afrontamiento se adquieren a través del entorno familiar”, subraya Orgilés.

“Aplicamos una batería de pruebas al comienzo, justo después de terminar el programa y al año. Tras un trabajo estadístico pormenorizado, hemos podido concluir que se han alcanzado muy buenos resultados”, aclara la investigadora. En la segunda edición, se está llevando a cabo una versión individual del pro-
grama, centrado en menores que por la gravedad del problema que presentan necesitan una atención más personalizada. En esta ocasión, se adapta el programa a la necesidad concreta y el seguimiento por parte del terapeuta es mayor. Por ahora, se ha adaptado a 15 niños y se han obtenido, de nuevo, muy buenos resultados, tal y como apunta Orgilés, quien también comenta que, de cara al próximo año, su intención es generalizar la modalidad individual. Además, el Plan Nacional de I+D+i del Ministerio de Economía y Competitividad ha concedido financiación para un proyecto que da continuidad al programa y que consiste en desarrollar la versión online de Super Skills. “La idea es diseñar un videojuego online, interactivo y multimedia, muy atractivo para los niños, al que se accedería con una clave personal, desde casa, a las ocho sesiones semanales. Estará igualmente supervisado, como en la versión presencial, por un terapeuta, que también ofrecerá información a los padres”, detalla la profesora.
En España, la UMH es pionera en la aplicación de Super Skills. Según explica la investigadora, desde los inicios se hizo un gran esfuerzo por adaptar el programa a la versión española, ya que los ejemplos en uno y otro caso, por la diferencia cultural, no terminaban de encajar. Por ejemplo, algunos juegos o comidas típicas que aparecían en las fichas anglosajonas podían resultar ajenas a los niños. Además, tal y como explica Orgilés, la idea de que sean dos personajes caracterizados como niños que han adquirido superpoderes emocionales los que guían a los menores en todo el proceso también es una propuesta original de los profesores de la UMH.
“Son modelos de afrontamiento, es decir, niños que también han tenido las mismas dificultades que los que van a llevar a cabo el programa y que, paso a paso, y a través del conjunto de actividades, las van superando. Esto no está en el programa original ni en ninguna de las adaptaciones europeas y ha resultado muy positivo”, explica.
Tal y como desarrolla Orgilés, el manual sobre el que se apoya el programa también ha sido ampliado por el equipo de la UMH, con el objetivo de que los terapeutas lo pudieran seguir sin ningún tipo de problema: “Por ejemplo, los niños protagonistas, Lisa y Mario, al principio se ponen muy nerviosos porque tienen que hablar en público y esto les genera ansiedad, pero a través de la relajación, van adquiriendo calma y aprendiendo a afrontar el reto. Poco a poco, van desarrollando sus poderes y por eso al final aparecen vestidos con capa y antifaz. De hecho, en la última sesión con los niños, también se les viste de superhéroes, como símbolo de todas las habilidades que han adquirido a lo largo de las sesiones. Una actividad que les resulta muy divertida y enriquecedora”, comenta la experta.
El tratamiento, totalmente gratuito, se aplica en la Clínica Universitaria de la UMH, sin embargo, también es posible aplicarlo en el centro escolar en el caso de que al menos 10 familias estén interesadas. Se lleva a cabo por psicólogas y psicólogos con amplia experiencia en psicología infanto-juvenil y se inicia con un cuestionario (accesible desde la web: superskills.edu.umh.es) que permite a los profesionales evaluar el estado emocional del niño.
Según explica Mireia Orgilés, entre los problemas más comunes que han detectado a lo largo de la aplicación del programa se encuentra la falta de recursos para afrontar situaciones complejas, causada en muchas ocasiones por la sobreprotección y que
genera que el niño se sienta vulnerable; la presión por cumplir ciertas expectativas, ya que la necesidad de que todo lo que hacen sea perfecto puede generar en el menor sensación de desasosiego o de que está decepcionando a sus padres y, por otra parte, la preocupación excesiva, que también se traduce en un niño que padece ansiedad y no termina de estar relajado. Y, también, según informa la experta, han aumentado los casos de niños con síntomas depresivos. El abanico de señales de alerta es variado: niños excesivamente preocupados, sin amigos, tristes, alicaídos, ansiosos, apáticos, que no sonríen… En definitiva, cualquier sintomatología relacionada con emociones negativas. Para Mireia Orgilés, la clave está en que el niño o niña adquiera los recursos necesarios para afrontar las diferentes situaciones de la vida, “porque esto le hará sentirse más seguro y, cuando le ocurra algo inesperado, sabrá cómo actuar”. La investigadora también opina que es importante que no haya un estilo educativo ni excesivamente estricto ni sumamente permisivo. Y que a la vez se fomente una comunicación fluida entre padres e hijos y un clima de confianza. “Y todo esto resulta complicado porque educar supone un gran reto”, recuerda la psicóloga.
El constaprograma de actividades,lecturas, juegos, role-playing y vídeos que ayudan a los me- nores a mejorar su estado emocionalMireia Orgilés y José Pedro Espada Profesores de Psicología de la Salud UMH Imágenes e ilustraciones cedidas por el Grupo AITANA de la UMH
La piel es la primera barrera corporal que se enfrenta al exterior. Desde contaminantes ambientales y cambios de temperatura hasta situaciones de estrés pueden provocar alteraciones dermatológicas como el prurito o la psoriasis. Los tratamientos actuales para paliar estas afecciones emplean derivados de la capsaicina, el principal componente activo de los chiles. Aunque alivia, este compuesto responsable del sabor picante de los pimientos puede provocar molestias intensas tras su aplicación inicial. Los investigadores del Instituto de Biología Molecular y Celular (IBMC) de la Universidad Miguel Hernández (UMH) de Elche Asia Fernández Carvajal y Antonio Ferrer Montiel han desarrollado nuevos compuestos derivados de la capsaicina para tratar estas alteraciones dermatológicas sin que existan las adversidades iniciales.
La investigadora del IBMC Asia Fernández Carvajal explica que la falta de tratamientos eficaces para algunas enfermedades de la piel se debe a que es un órgano todavía desconocido. “Su funcionamiento es casi tan complejo como el del cerebro”, señala la profesora de la UMH. En la dermis se producen numerosas interacciones en las que están implicados sistemas como el inmune o el sensorial. Tal y como cuenta la docente, enfermedades como la psoriaris tienen un componente relacionado con la alteración del sistema inmunitario y, también, con la liberación de sustancias excitatorias. Es decir, existen gran cantidad de reacciones y factores implicados en las afecciones de piel que no han sido descritas en profundidad.
El equipo de investigadores ha focalizado su trabajo en la actividad de un tipo de proteína transmembrana -capaz de traspasar la bicapa lipídica de la membrana celular-, denominada canal iónico TRPV1, que aumenta en condiciones patológicas de dolor e inflamación y, por este motivo, su modulación supone un desafío en la generación de nuevas terapias más seguras y efectivas. Estos canales también están implicados en el prurito o la psoriasis. En el estudio, financiado por los proyectos de I+D+I “Retos de la sociedad”
del Ministerio de Economía, Industria y Competitividad, ha participado también la profesora de la Universidad del Piamonte Orientale en Novara (Italia) Tracey Pirali, responsable de la síntesis química de los compuestos.
La capsaicina actúa sobre el canal TRPV1, con potencial para aliviar una gran cantidad de afecciones de la piel asociadas a la hiperalgesia -sensación muy elevada de dolor- la inflamación o el prurito. Como el intenso dolor inicial tras su aplicación limita su uso, queda comprometida también su eficacia terapéutica. Por este motivo, el objetivo de los investigadores es desarrollar compuestos modificados de la capsaicina capaces de inactivarse por las enzimas en la piel y evitar algunos de estos efectos secundarios, sin que pierdan su capacidad de aliviar el dolor y el picor.

Fernández Carvajal señala que, además, la aplicación crónica de la capsaicina produce su acumulación en la piel, induce eritema e incluso puede fomentar la formación de tumores de piel cuando se combinan con un inductor como la luz solar. “Por otro lado, los compuestos que bloquean el canal TRPV1 han mostrado efectos adversos preocupantes como es un aumento elevado de la temperatura corporal, lo que ha limitado su aplicación en clínica”, subraya Fernández.

investigadores de la UmH desarrollan compuestos derivados de la capsaicina que pueden aliviar el prurito o la psoriasis
Mejorar los tratamientos actuales Los efectos indeseados de los compuestos utilizados en la actualidad impulsan la necesidad de nuevas estrategias terapéuticas. En este sentido, los grupos de investigación de la UMH y de la Università del Piemonte Orientale han sintetizado una variedad de derivados de la capsaicina con un interruptor de autodestrucción incorporado en laboratorio, con el objetivo de aliviar el dolor y picor de forma local y evitar algunos de estos efectos secundarios. “El interruptor consiste en la adicción de un enlace éster en los compuestos mediante la reacción de Passerini, un tipo de reacción que favorece la eliminación de las moléculas en el cuerpo”, explica Asia Fernández”. De esta forma, las enzimas esterasas presentes en piel hidrolizan el enlace y producen metabolitos que el cuerpo elimina de manera sencilla. Es decir, estas enzimas modificadas ayudan al organismo a eliminar las moléculas que causan efectos adversos sin desvirtuar sus efectos beneficiosos.
Los compuestos han sido probados en líneas celulares para evaluar su efecto sobre la actividad del canal TRPV1 y en células de piel humana para determinar su hidrólisis. Según la profesora de la UMH, han demostrado ser capaces de aliviar el dolor y el picor en modelos animales de inflamación y prurito sin producir hipertermia.
La profesora de la UMH cuenta que varias enfermedades de la piel que cursan con prurito suelen ser muy resistentes a las terapias antihistamínicas: “Actualmente se carece de un tratamiento farmacológico que se pueda aplicar de forma fácil, que se tolere bien y

que sea universalmente eficaz para paliar el picor persistente”. En este sentido, Asia Fernández asegura que esta afección es motivo frecuente de consulta en atención primaria y causa un gran deterioro en la calidad de vida, especialmente cuando es crónico.
Durante los últimos años, el síndrome de la piel sensible se ha convertido en uno de los campos más importantes en dermatología para el que no existe actualmente un tratamiento eficaz.

Producir nuevos fármacos
El empleo de una nueva diana implicada en los procesos de pruritogénesis, el canal iónico TRPV1 y su modulación mediante compuestos hidrolizables derivados de la capsaicina puede ser una estrategia innovadora y de gran alcance para la prevención y el tratamiento de estos trastornos dermatológicos, lo que evitaría los efectos secunda-
rios que hasta ahora se han producido en el desarrollo de compuestos moduladores de TRPV1.
El estudio, que todavía se encuentra en fase inicial, avanza hacia la fase clínica. Asia Fernández explica que esperan testar los compuestos el próximo año. “Primero, trabajaremos con personas que no padecen prurito o psoriasis, para constatar que no produce efecto adverso”, cuenta. Después, los investigadores continuarán con las pruebas en pacientes que sí padecen las patologías y comprobarán si la molécula es efectiva. Como asegura la investigadora de la UMH, el camino hasta producir un fármaco comercializable es largo, porque además de demostrar que es seguro y eficaz, es indispensable que su precio no sea elevado y que pueda producirse fácilmente en grandes cantidades.
“C omo en casa en ningún sitio”, eso pienso siempre que salgo en vacaciones. Me encanta viajar, eso sí, pero pienso que vivo en el mejor lugar del mundo, con las mejores personas, el mejor clima (sí, los mejores 40ºC a la sombra), las mejores fiestas (“las fiestas de mi pueblo son las mejores”, eso dicen todxs). Parece todo una opinión sesgada, y lo es, siempre lo es. No porque sea mentira, sino porque nuestro mundo lo percibimos con sensaciones, sentidos, variables inexactas. Las matemáticas son absolutas, pero el resto de cosas no. “Todo es relativo”, es lo típico que se dice de Einstein (menos la velocidad de la luz). Pero casi nunca nos referimos al tiempo, ni a la gravedad. Si digo que mi provincia es la mejor del mundo es una sensación, pero es inexacto. Todo depende, que diría Pau Donés, haciendo otro guiño al sabio con la lengua fuera.
¿Eres rico? ¿Eres guapo? ¿Juegas bien al fútbol? Todo esto depende de con quién lo compares, y sobre todo, de lo que tengas alrededor. Y decir cuál es la mejor opción entre varias no siempre es sencillo. Porque la naturaleza busca engañarte para sobrevivir. Por eso existen plantas carnívoras, setas venenosas, o, por ejemplo, la lagartija colirroja. La Acanthodactylus erythrurus desarrolla una coloración rojiza en su cola y patitas de atrás para atraer a los depredadores a zonas no vitales. Esto se llama “efecto señuelo”. La naturaleza dotó a esta especie de una característica que dominó ante otras por su ventaja evolutiva.
Pero con los números también hay señuelos. En marketing se utiliza todo el rato el “efecto señuelo”. Cada vez que hay rebajas (¿acaso habéis comparado con el precio que había antes?), cada cartel de oferta 3x2 (que son 6), o cosas más sutiles. Otros señuelos juegan con que no comprobamos los resultados. Muy mal.
Por ejemplo, 1 litro de helado (de turrón, a ser posible) cuesta 10€, medio litro cuesta 4€. Claramente cogemos el de medio litro y si queremos 1 litro cogemos dos de medio litro y nos sale a 8€. Aquí parece claro.
Pero, y si ponen 0’80 litros por 7€... ¿Es una ganga o es un señuelo? Hacemos cuentas que eso no engaña. Vamos a sacar un número entero de litros con grupos 0’80 litros, tendríamos que tener 5 paquetes y comprar 4 litros de helado, es decir, sería 5·7€=35€. Pues eso mismo, los 4 litros, en 8 paquetes de medio litro nos daría 8*4€=32€. Por tanto, sigue siendo más barato el de medio litro. El otro no era una ganga, ¡era un señuelo! Claro que pocas veces nos ponemos a hacer estas cuentas en el supermercado, porque tenemos poco tiempo o por impaciencia. Pero como todo es relativizar. Bueno, todo menos la velocidad de la luz y las Matemáticas.
También hay algunos señuelos que nos sirven para echarnos unas risas. Usad las Matemáticas, que no nos engañen, que nos digan la verdad...

En algunas ocasiones, se utiliza el Marketing para confundir productos y elegir el ejemplar menos malo entre los posibles. Por ejemplo, si tenemos memoria USB de 8 Gb por 5€, y otra de 32 Gb por 30€, es posible que el de 32 Gb nos parezca excesivo gasto y compremos el de 8 Gb. Pero si añadimos un tercer producto, una memoria USB de 24 Gb por 35€, este último sería un producto señuelo, y hace parecer más atractivo el de 32 Gb. Los números y la psicología, ese mundo de engaño y subjetividad.
Por eso es importante saber Matemáticas, no sólo Aritmética básica, sino la actitud matemática de por sí. Con una actitud matemática no te van a engañar fácilmente, esa actitud te hace inteligente y te permite distinguir entre la verdad y la mentira, entre lo bonito y lo que “parece bonito”. Esto es posible que me pase con el lugar donde vivo, es posible, pero necesito seguir estudiando su belleza. Todo es tan relativo (menos la velocidad de la luz y las Matemáticas, ojo).

Fernández Carvajal: “Se carece de un tratamiento para paliar el persistenteprurito que sea de fácil aplicación y se tolere bien”



*Según un estudio de la fundación BBVA y el Instituto Valenciano de Investigaciones Económicas.